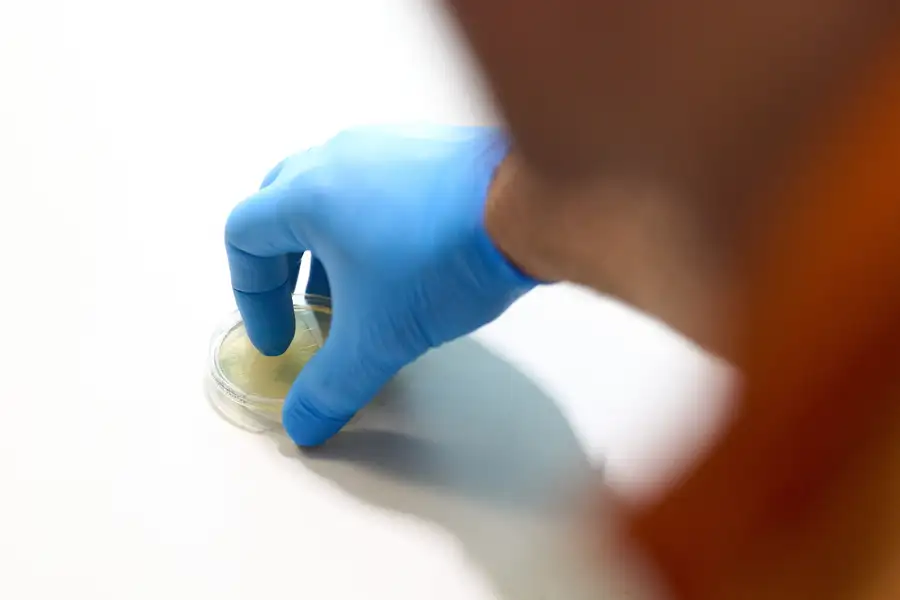

Hygieneinspektion
Eine Hygieneinspektion an RLT-Anlagen, also an raumlufttechnischen Anlagen, ist wichtig und gesetzlich vorgeschrieben, um die hygienischen Standards und die Qualität der Raumluft sicherzustellen.
Hier sind einige Gründe, wozu eine Hygieneinspektion an RLT-Anlagen benötigt wird:
Gesundheitliche Aspekte
Eine schlechte Raumluftqualität kann gesundheitliche Probleme wie Allergien, Atemwegsbeschwerden und Infektionen verursachen. Eine regelmäßige Inspektion der RLT-Anlagen gewährleistet, dass die Raumluft frei von schädlichen Partikeln, Bakterien und anderen Verunreinigungen ist.
Einhaltung von Vorschriften
RLT-Anlagen müssen den gesetzlichen Bestimmungen und Richtlinien entsprechen. Eine Hygieneinspektion stellt sicher, dass die Anlagen den Anforderungen der relevanten Normen und Verordnungen entsprechen.
Energieeffizienz
Eine regelmäßige Inspektion der RLT-Anlagen kann helfen, Energieeinsparungen zu erzielen. Überprüfungen können dazu beitragen, dass die Anlagen effizient arbeiten und den Energieverbrauch minimieren.
Vermeidung von Schäden
Durch eine regelmäßige Inspektion können potenzielle Probleme frühzeitig erkannt und behoben werden, bevor es zu größeren Schäden kommt. Dies trägt zur längeren Lebensdauer der Anlagen bei und verhindert teure Reparaturen.
Arbeitsplatzsicherheit
Eine optimale Raumluftqualität in Arbeitsumgebungen ist wichtig für das Wohlbefinden und die Leistung der Mitarbeiter. Hygieneinspektionen stellen sicher, dass die Arbeitsumgebung frei von Schadstoffen ist und den Gesundheits- und Sicherheitsstandards entspricht.
Insgesamt dient eine Hygieneinspektion an RLT-Anlagen der Gesundheit, Sicherheit und Effizienz in Gebäuden. Sie hilft, potenzielle Risiken zu minimieren und eine gute Qualität der Raumluft zu gewährleisten.